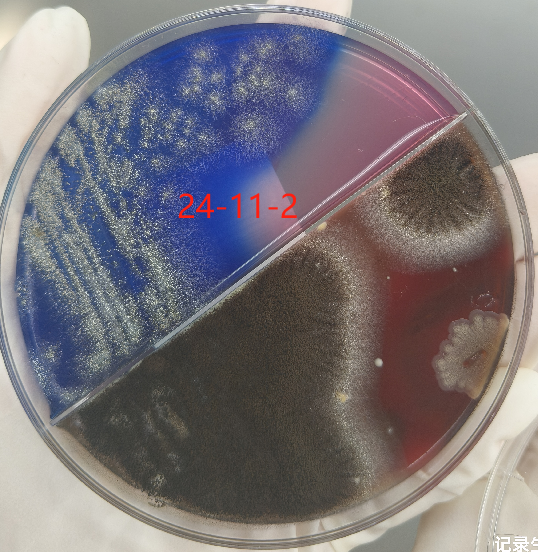
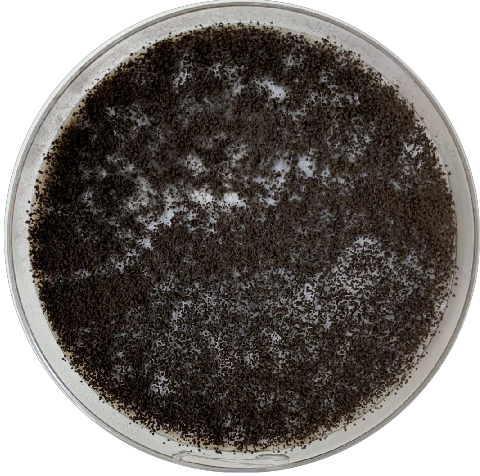

耳痛持续发作,究竟是什么使患者如此困扰?细菌?病毒?真菌?具体什么原因,我们需要一些检验检查手段来帮助我们侦破“案件”。
一、病史介绍
患者王某某,男,55岁,因“右耳疼痛耳堵耳闷7天”于2024-10-31 14:40入院。
现病史:患者缘于7天前无明显原因及诱因出现右耳疼痛,右耳耳堵耳闷,听力下降,耳鸣,持续性“嗡嗡”样声响,左耳较前无明显异常,无头痛,无头晕,无发热,静点抗炎药物治疗(具体名剂不详),症状无明显缓解。今为求系统治疗而来我院,门诊检查后以“急性外耳道炎(右)”收入耳鼻咽喉科住院治疗。
二、耳内镜示情况
右侧外耳道弥漫性充血,肿胀,潮湿,可见积中等量灰白色分泌物,鼓膜充血,见图1。


图1 2024年10月31日耳内镜
三、实验室检查
表1实验室生化检查结果
项目结果参考范围结果解读
血糖Mmol/L 8.0 3.9`6.1有糖尿病史
表2实验室血常规及CRP检查结果
项目结果参考范围结果解读
超敏C-反应蛋白Mg/L 3.75<10.0不支持炎症反应
红细胞(RBC)10×12/L 5.26 4.3~5.8
白细胞(WBC)10×9/L 8.58 3.5`9.5不支持炎症反应
血红蛋白(HGB)G/L 165 130`170
患者无炎症反应,但有耳堵、耳闷、耳内肿胀等症状,结合耳内镜情况,考虑进行耳道分泌物检查。
四、微生物检查
11月1日,采集耳道分泌物送微生物室培养检查。
11月2日,血平板生长黑褐色絮状菌落,背面带白色绒毛,见图2。粘取菌落压片,经乳酸酚棉蓝染色后,镜下可见:黑色球形放射状孢子头,有单层无色瓶梗,梗基呈放射状,见图3。
图2血平板35℃1天

图3镜下形态乳酸酚棉兰染色×400
微生物检验结果为黑曲霉菌,经与临床及时沟通,确诊为右侧真菌性外耳道炎(黑曲霉感染)。
转种到沙氏培养基,沙氏琼脂上生长迅速,3d内成熟,开始为白色绒毛状,菌落中央逐渐出现很淡的黄色,第五天,变成粗绒状黑色,背面呈淡黄色,见图4。
图4沙保罗培养35℃5天
五、鉴别诊断
1.急性化脓性中耳炎。起病急骤,突然发热,耳内剧烈疼痛,还可伴有耳聋和耳鸣,由外耳道流出脓性分泌物,一般流脓后体温逐渐恢复正常,耳痛减轻,抗生素有效;
2.真菌性外耳道炎。无发热,外耳道肿胀或奇痒,有阻塞感,耳堵耳闷,分泌物呈水样,严重时可有听觉障碍,抗生素无效。
六、患者预后
经过洁耳以及规范使用药物治疗后,患者耳部症状得到了很大的改善,且耳镜复检未见白色分泌物。
七、微生物知识拓展
1黑曲霉(A.niger)。属曲霉属,黑曲霉群。25—30℃在马铃薯葡萄糖琼脂培养基上菌落生长迅速,10天左右菌落可达2.5-3厘米,菌落初为白色,常有鲜黄色区域,厚绒状,继而黑色,背面无色或中央部分略带褐色。在沙氏琼脂上生长迅速,3d内成熟,开始为白色绒毛状,菌落中央逐渐出现很淡的黄色,继而变成粗绒状黑色或黑褐色,背面无色或者淡黄色,见图2至图4。其以菌落颜色黑色(niger)命名。
2易感因素。(1)不洁挖耳习惯。许多人有挖耳朵的习惯性,从而为真菌感染创造了有利条件。(2)耳道长期潮湿。如果耳道长时间保持潮湿,容易促进真菌生长,导致感染。(3)长期使用抗菌药。长期使用抗菌药物可能导致耳道内正常菌群失衡,从而使得真菌有机可乘。(4)环境因素。潮湿气候特别适合真菌生长,在这种环境下,如果耳道卫生状况不佳,更易引发耳真菌病。
综上所述,黑曲霉是免疫力正常人耳真菌病感染中最常见的分离菌,其病变的部位容易取样,属于浅表感染,诊断更为直接。然而真菌可以感染人体的所有器官,感染程度从慢性、轻度至急性,甚至危及生命,黑曲霉也不例外。通过此病例,检验人员应走进临床,及时进行临床沟通,尽早确诊,尽早治疗,缩短疗程,减轻患者痛苦与经济负担。为此作为基层临床人员,正确认识微生物标本的送检与培养至关重要,同时还要提高检验人员对真菌鉴定与鉴别能力,更好的帮助临床捉拿真凶。
董晶晶 河北省玉田县中医医院检验科



